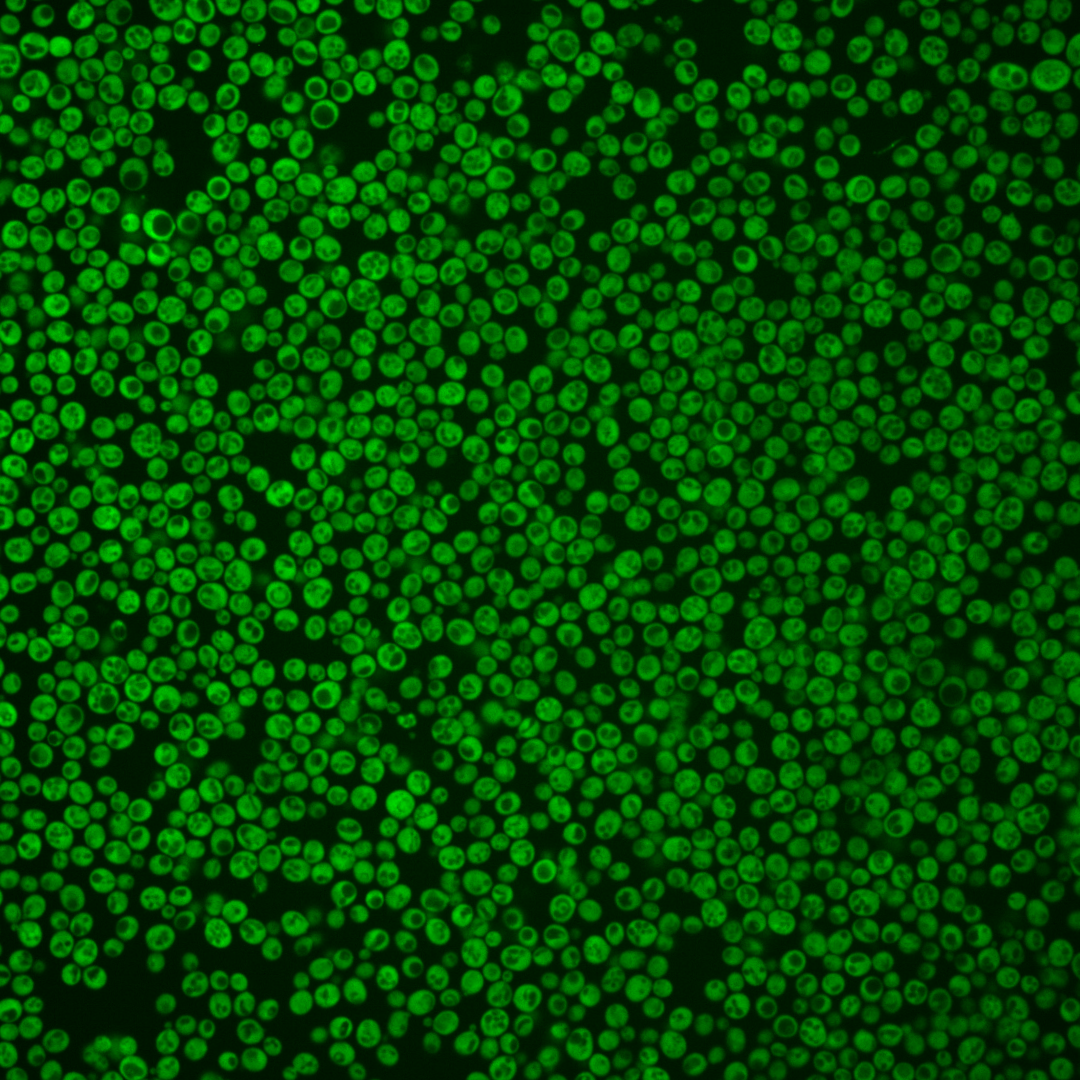
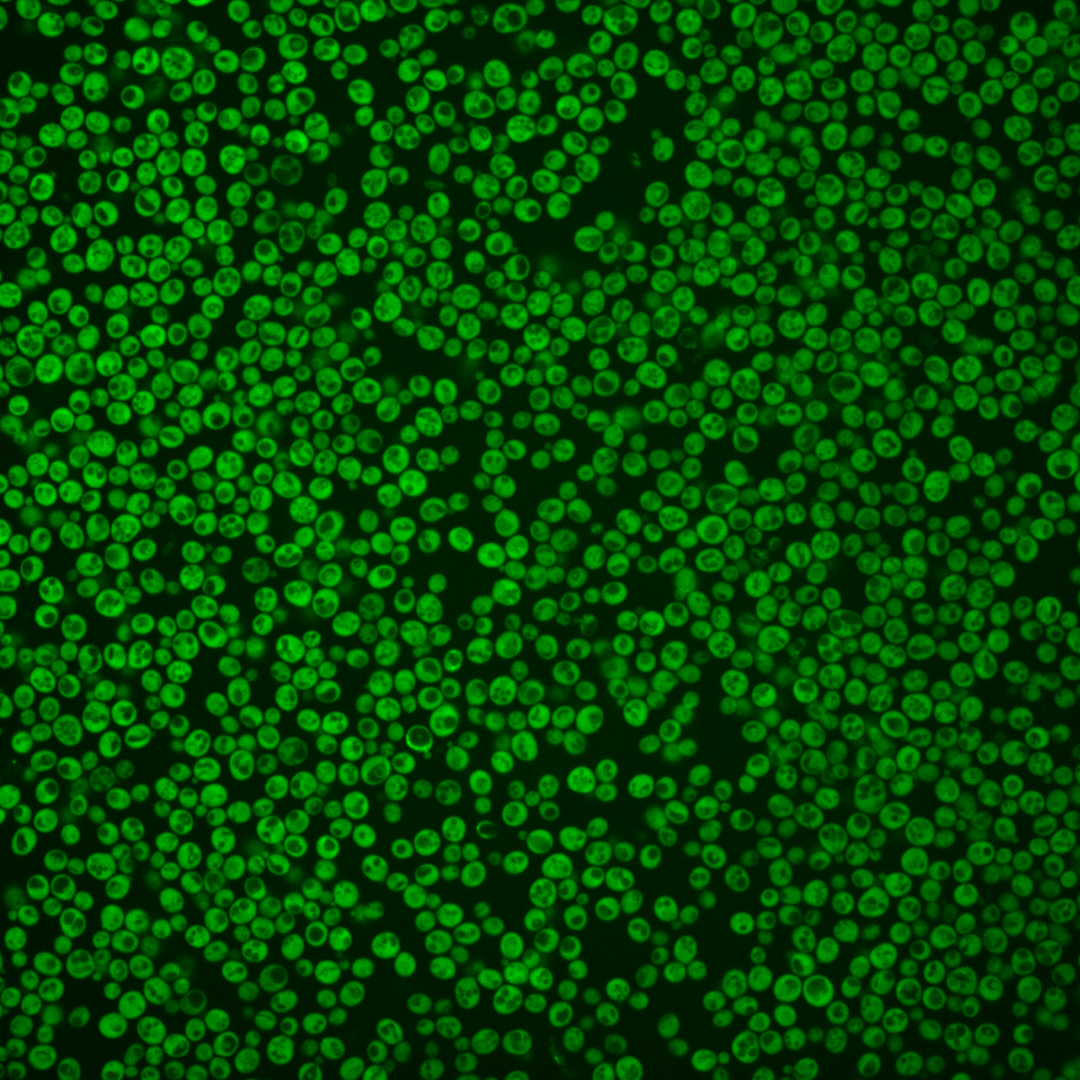
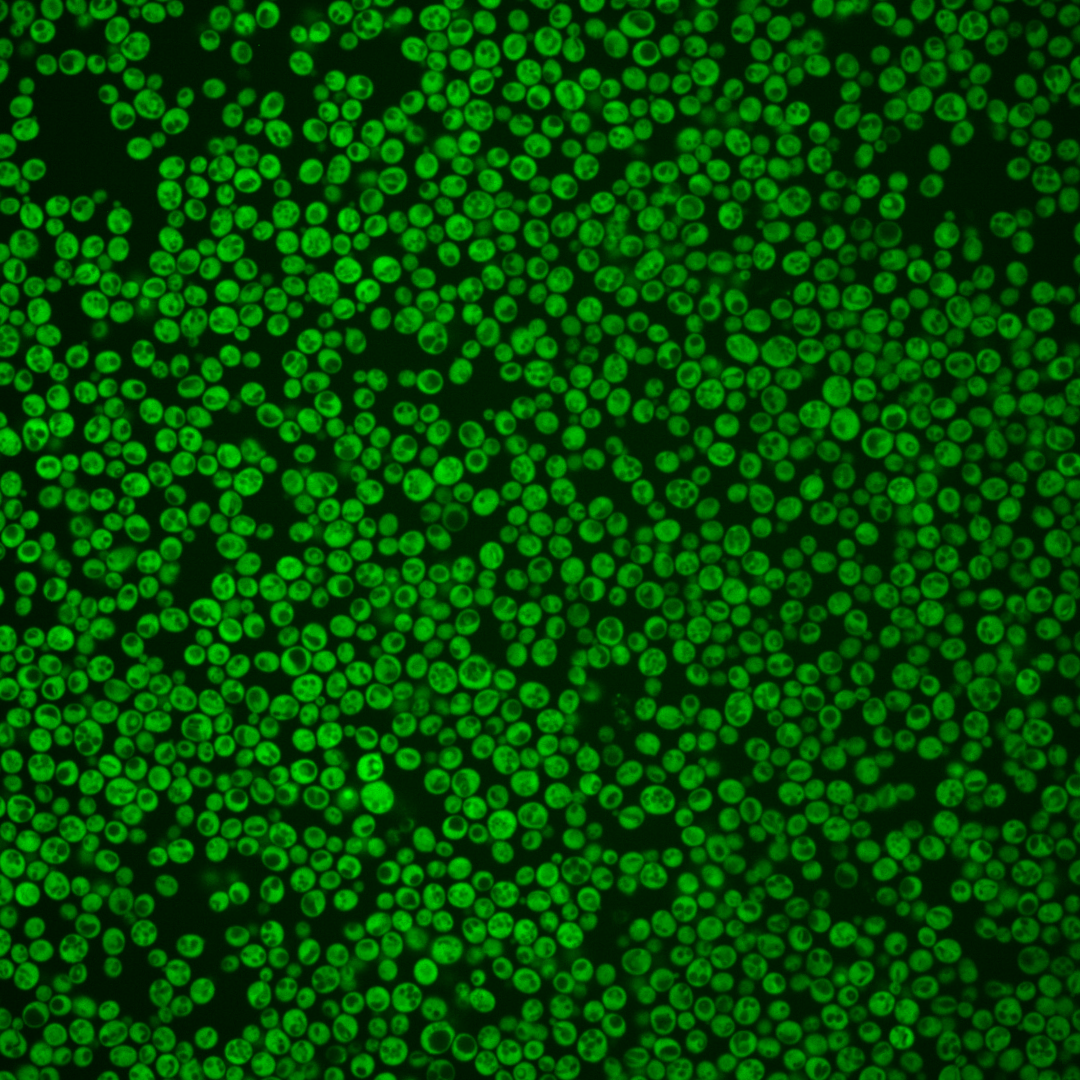
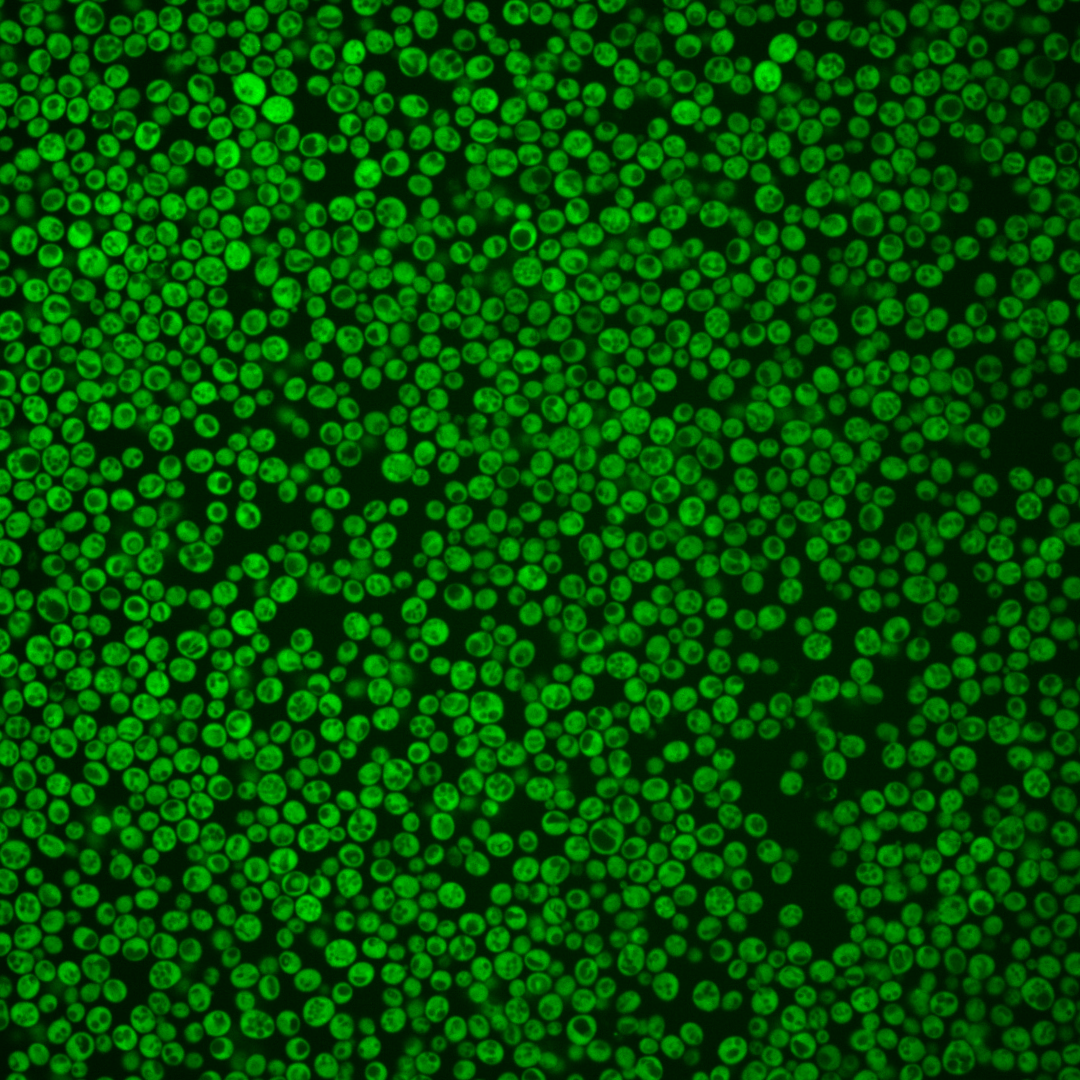
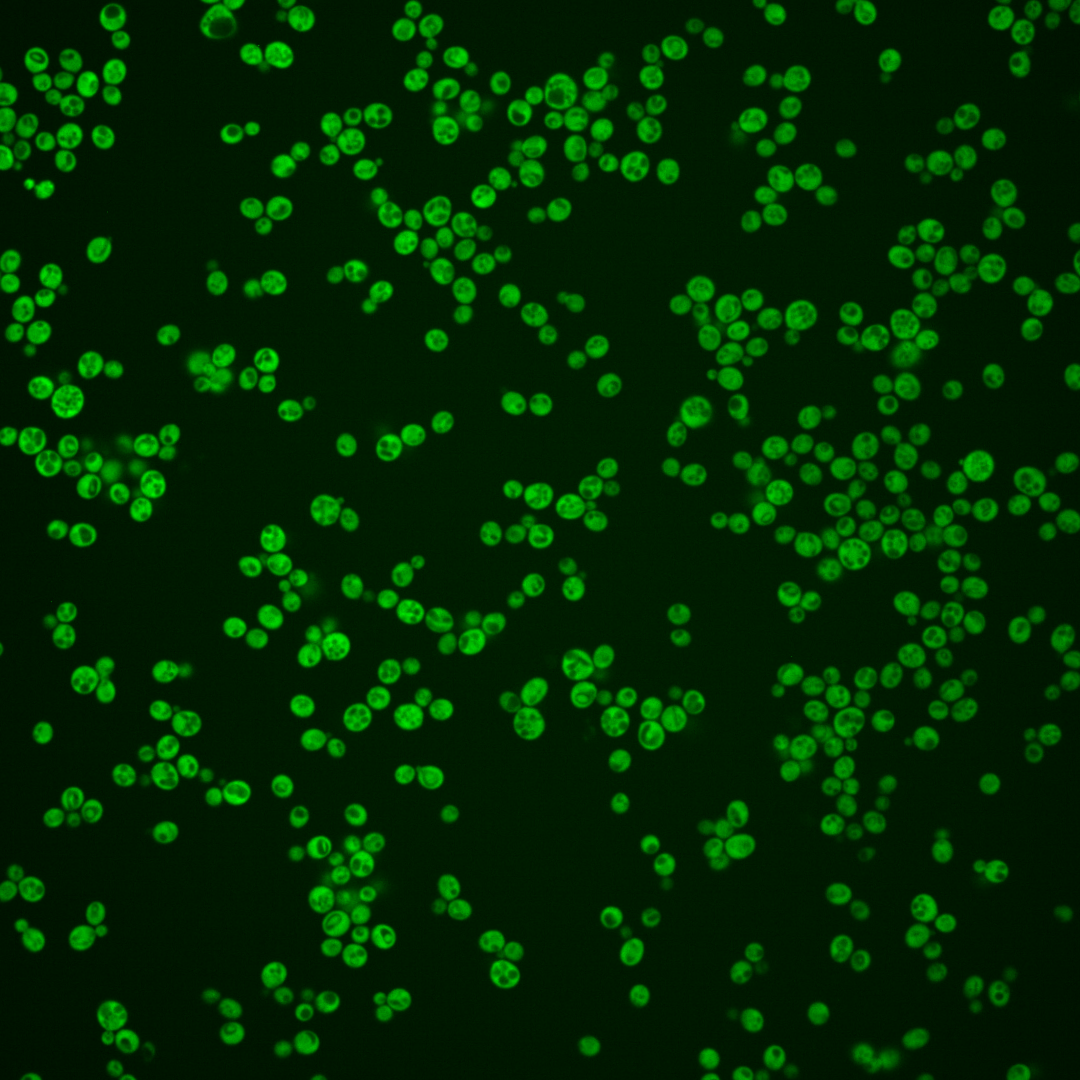
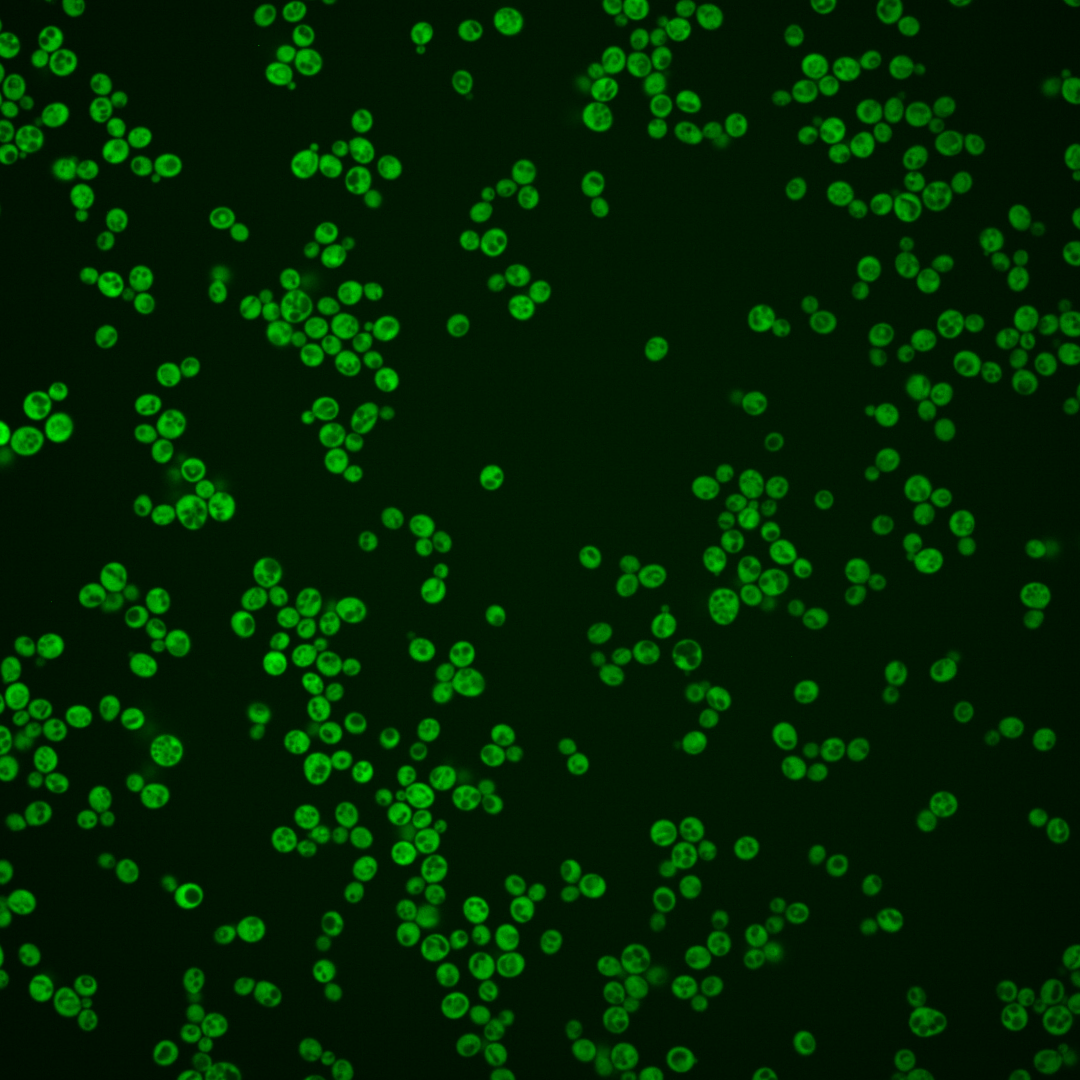
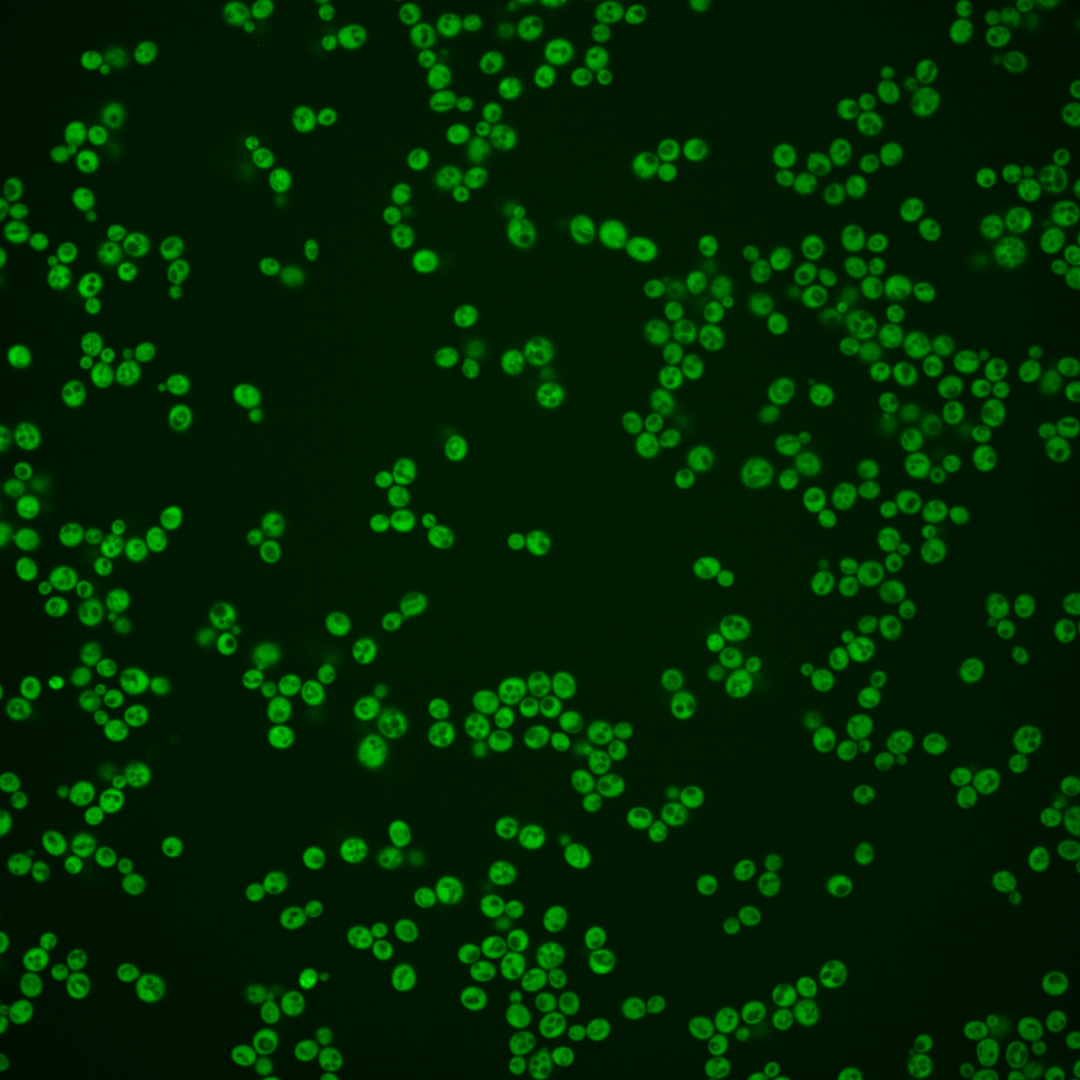
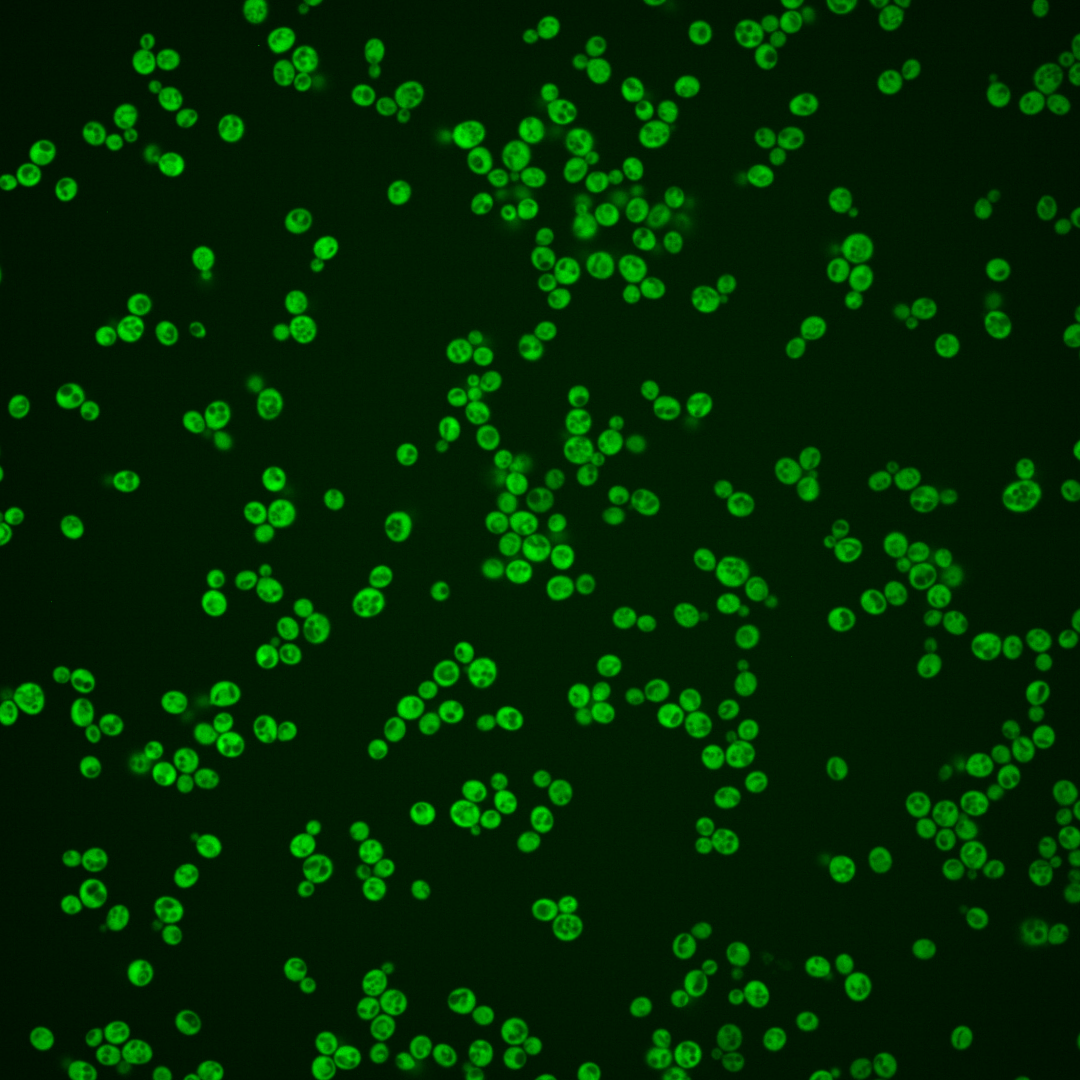

| Standard name | |
|---|---|
| Human Ortholog | |
| Description | Essential Hsp90p co-chaperone; necessary for passage through the START phase of the cell cycle; stabilizes protein kinase nascent chains and participates along with Hsp90p in their folding |
Micrographs




















































































Sub-cellular Localization
Yeast GFP Assignment
Protein Abundance
Localization Change
External localization resources
| ensLOC | DeepLoc | |||||||||||||||||||||||
|---|---|---|---|---|---|---|---|---|---|---|---|---|---|---|---|---|---|---|---|---|---|---|---|---|
| Localization | WT1 | WT2 | WT3 | RAP60 | RAP140 | RAP220 | RAP300 | RAP380 | RAP460 | RAP540 | RAP620 | RAP700 | HU80 | HU120 | HU160 | rpd3Δ_1 | rpd3Δ_2 | rpd3Δ_3 | WT1 | WT2 | WT3 | AF100 | AF140 | AF180 |
| Cortical Patches | 0 | 0 | 0 | 0 | 0 | 0 | 1 | 5 | 5 | 1 | 5 | 2 | 0 | 1 | 0 | 0 | 0 | 0 | 0 | 0 | 0 | 0 | 0 | 0 |
| Bud | 0 | 1 | 6 | 1 | 3 | 0 | 2 | 2 | 2 | 1 | 0 | 1 | 3 | 2 | 0 | 0 | 0 | 0 | 0 | 1 | 0 | 0 | 0 | 2 |
| Bud Neck | 0 | 0 | 0 | 0 | 0 | 0 | 0 | 0 | 0 | 0 | 0 | 0 | 0 | 0 | 0 | 0 | 0 | 0 | 0 | 0 | 1 | 0 | 0 | 0 |
| Bud Site | 0 | 0 | 0 | 0 | 0 | 0 | 0 | 0 | 0 | 0 | 0 | 0 | 0 | 0 | 0 | 0 | 0 | 0 | – | – | – | – | – | – |
| Cell Periphery | 3 | 12 | 2 | 0 | 2 | 5 | 6 | 8 | 21 | 16 | 11 | 18 | 38 | 15 | 23 | 11 | 7 | 6 | 0 | 0 | 0 | 0 | 0 | 0 |
| Cytoplasm | 268 | 376 | 157 | 102 | 152 | 143 | 159 | 184 | 135 | 139 | 75 | 109 | 459 | 620 | 575 | 340 | 232 | 121 | 258 | 364 | 150 | 261 | 365 | 374 |
| Endoplasmic Reticulum | 0 | 3 | 0 | 0 | 2 | 1 | 4 | 16 | 15 | 16 | 8 | 8 | 2 | 6 | 4 | 9 | 6 | 5 | 3 | 0 | 5 | 1 | 4 | 20 |
| Endosome | 0 | 0 | 0 | 0 | 0 | 0 | 1 | 0 | 0 | 0 | 0 | 0 | 0 | 0 | 0 | 0 | 0 | 0 | 0 | 1 | 0 | 0 | 1 | 3 |
| Golgi | 0 | 1 | 0 | 0 | 0 | 0 | 0 | 0 | 0 | 0 | 0 | 0 | 0 | 0 | 0 | 0 | 2 | 0 | 0 | 1 | 0 | 0 | 0 | 2 |
| Mitochondria | 0 | 2 | 1 | 2 | 4 | 3 | 16 | 13 | 22 | 32 | 15 | 34 | 0 | 0 | 1 | 5 | 1 | 0 | 0 | 1 | 1 | 0 | 0 | 1 |
| Nucleus | 0 | 0 | 0 | 0 | 0 | 1 | 1 | 1 | 2 | 0 | 0 | 0 | 0 | 0 | 1 | 0 | 2 | 2 | 0 | 0 | 0 | 0 | 1 | 0 |
| Nuclear Periphery | 0 | 0 | 0 | 0 | 0 | 0 | 0 | 0 | 0 | 2 | 1 | 1 | 0 | 0 | 0 | 0 | 0 | 0 | 0 | 0 | 0 | 0 | 0 | 3 |
| Nucleolus | 0 | 0 | 0 | 0 | 0 | 0 | 0 | 0 | 0 | 0 | 0 | 0 | 0 | 0 | 0 | 0 | 0 | 0 | 0 | 0 | 0 | 0 | 0 | 0 |
| Peroxisomes | 0 | 0 | 0 | 0 | 0 | 0 | 0 | 0 | 0 | 0 | 0 | 0 | 0 | 0 | 0 | 0 | 0 | 0 | 0 | 0 | 0 | 0 | 0 | 0 |
| SpindlePole | 0 | 0 | 0 | 0 | 0 | 0 | 0 | 0 | 0 | 0 | 0 | 0 | 0 | 0 | 0 | 0 | 0 | 0 | 0 | 0 | 0 | 0 | 0 | 0 |
| Vac/Vac Membrane | 0 | 0 | 1 | 0 | 2 | 0 | 8 | 2 | 1 | 8 | 1 | 4 | 3 | 1 | 2 | 6 | 8 | 2 | 0 | 2 | 4 | 2 | 4 | 5 |
| Unique Cell Count | 269 | 379 | 159 | 103 | 155 | 149 | 183 | 214 | 176 | 184 | 100 | 150 | 463 | 627 | 586 | 349 | 242 | 125 | 265 | 376 | 167 | 269 | 382 | 421 |
| Labelled Cell Count | 271 | 395 | 167 | 105 | 165 | 153 | 198 | 231 | 203 | 215 | 116 | 177 | 505 | 645 | 606 | 371 | 258 | 136 | 265 | 376 | 167 | 269 | 382 | 421 |
Yeast GFP Assignment
Protein Abundance
| Screen | WT1 | WT2 | WT3 | RAP60 | RAP140 | RAP220 | RAP300 | RAP380 | RAP460 | RAP540 | RAP620 | RAP700 | HU80 | HU120 | HU160 | rpd3Δ_1 | rpd3Δ_2 | rpd3Δ_3 | AF100 | AF140 | AF180 |
|---|---|---|---|---|---|---|---|---|---|---|---|---|---|---|---|---|---|---|---|---|---|
| Mean Cell GFP Intensity (1e-4) | 17.3 | 17.1 | 12.6 | 12.4 | 13.0 | 13.1 | 10.5 | 10.9 | 10.6 | 10.2 | 9.7 | 9.9 | 18.9 | 18.8 | 19.1 | 16.5 | 20.6 | 22.1 | 16.2 | 17.2 | 18.8 |
| Std Deviation (1e-4) | 2.6 | 3.5 | 2.3 | 2.1 | 2.8 | 2.6 | 2.6 | 2.5 | 2.0 | 2.6 | 2.0 | 2.4 | 3.4 | 3.8 | 4.0 | 5.8 | 7.4 | 7.9 | 3.0 | 3.5 | 4.2 |
| Intensity Change (Log2) | – | – | – | -0.02 | 0.05 | 0.05 | -0.27 | -0.21 | -0.25 | -0.3 | -0.37 | -0.35 | 0.59 | 0.58 | 0.6 | 0.39 | 0.71 | 0.81 | 0.37 | 0.45 | 0.58 |
Localization Change
| Localization | RAP60 | RAP140 | RAP220 | RAP300 | RAP380 | RAP460 | RAP540 | RAP620 | RAP700 | HU80 | HU120 | HU160 | rpd3Δ_1 | rpd3Δ_2 | rpd3Δ_3 |
|---|---|---|---|---|---|---|---|---|---|---|---|---|---|---|---|
| Cortical Patches | 0 | 0 | 0 | 0 | 0 | 0 | 0 | 0 | 0 | 0 | 0 | 0 | 0 | 0 | 0 |
| Bud | 0 | 0 | 0 | 0 | 0 | 0 | 0 | 0 | 0 | 0 | 0 | 0 | 0 | 0 | 0 |
| Bud Neck | 0 | 0 | 0 | 0 | 0 | 0 | 0 | 0 | 0 | 0 | 0 | 0 | 0 | 0 | 0 |
| Bud Site | 0 | 0 | 0 | 0 | 0 | 0 | 0 | 0 | 0 | 0 | 0 | 0 | 0 | 0 | 0 |
| Cell Periphery | 0 | 0 | 0 | 0 | 0 | 3.9 | 3.1 | 3.5 | 3.8 | 3.1 | 0 | 1.7 | 0 | 0 | 0 |
| Cytoplasm | 0.2 | -0.5 | -1.5 | -4.1 | -4.4 | -6.0 | -6.2 | -6.1 | -6.6 | 0.4 | 0.1 | -0.5 | -0.9 | -1.7 | -1.1 |
| Endoplasmic Reticulum | 0 | 0 | 0 | 0 | 3.5 | 3.8 | 3.8 | 0 | 0 | 0 | 0 | 0 | 0 | 0 | 0 |
| Endosome | 0 | 0 | 0 | 0 | 0 | 0 | 0 | 0 | 0 | 0 | 0 | 0 | 0 | 0 | 0 |
| Golgi | 0 | 0 | 0 | 0 | 0 | 0 | 0 | 0 | 0 | 0 | 0 | 0 | 0 | 0 | 0 |
| Mitochondria | 0 | 0 | 0 | 3.4 | 2.7 | 4.3 | 5.2 | 4.7 | 6.1 | 0 | 0 | 0 | 0 | 0 | 0 |
| Nucleus | 0 | 0 | 0 | 0 | 0 | 0 | 0 | 0 | 0 | 0 | 0 | 0 | 0 | 0 | 0 |
| Nuclear Periphery | 0 | 0 | 0 | 0 | 0 | 0 | 0 | 0 | 0 | 0 | 0 | 0 | 0 | 0 | 0 |
| Nucleolus | 0 | 0 | 0 | 0 | 0 | 0 | 0 | 0 | 0 | 0 | 0 | 0 | 0 | 0 | 0 |
| Peroxisomes | 0 | 0 | 0 | 0 | 0 | 0 | 0 | 0 | 0 | 0 | 0 | 0 | 0 | 0 | 0 |
| SpindlePole | 0 | 0 | 0 | 0 | 0 | 0 | 0 | 0 | 0 | 0 | 0 | 0 | 0 | 0 | 0 |
| Vacuole | 0 | 0 | 0 | 0 | 0 | 0 | 0 | 0 | 0 | 0 | 0 | 0 | 0 | 0 | 0 |
External localization resources
Images






























Protein Concentration and Protein Localization Data
| R1 | R2 | R3 | ||||||||||||||||
|---|---|---|---|---|---|---|---|---|---|---|---|---|---|---|---|---|---|---|
| G1 Pre-START | G1 Post-START | S/G2 | Metaphase | Anaphase | Telophase | G1 Pre-START | G1 Post-START | S/G2 | Metaphase | Anaphase | Telophase | G1 Pre-START | G1 Post-START | S/G2 | Metaphase | Anaphase | Telophase | |
| Concentration | 12.1451 | 16.1227 | 16.7693 | 13.1131 | 16.2824 | 16.9247 | 10.9229 | 14.1966 | 13.2479 | 13.3071 | 10.4332 | 12.8542 | 12.6262 | 17.9842 | 15.6777 | 16.3371 | 14.0914 | 16.3118 |
| Actin | 0.0153 | 0.046 | 0.0005 | 0.0224 | 0.0002 | 0.0008 | 0.0261 | 0.0062 | 0.017 | 0.0002 | 0.0107 | 0.0014 | 0.0378 | 0.0012 | 0.0172 | 0.0079 | 0.0569 | 0.0077 |
| Bud | 0.0002 | 0.0008 | 0.0001 | 0.0006 | 0.0002 | 0.0005 | 0.0003 | 0.0008 | 0.0001 | 0.0001 | 0.0003 | 0.0003 | 0.0005 | 0.0002 | 0.0005 | 0.0216 | 0.0003 | 0.0001 |
| Bud Neck | 0.0005 | 0.0005 | 0.0004 | 0.0006 | 0.0006 | 0.0015 | 0.0005 | 0.0002 | 0.0002 | 0.0002 | 0.0004 | 0.0008 | 0.0019 | 0.0002 | 0.0014 | 0.0006 | 0.0006 | 0.0014 |
| Bud Periphery | 0.0001 | 0.0008 | 0 | 0.0016 | 0 | 0.0003 | 0.0002 | 0.0002 | 0 | 0 | 0.0001 | 0.0003 | 0.0006 | 0 | 0.0004 | 0.0062 | 0.0002 | 0.0001 |
| Bud Site | 0.0008 | 0.0023 | 0.0001 | 0.0015 | 0 | 0.0001 | 0.004 | 0.002 | 0.0002 | 0 | 0.0005 | 0.001 | 0.0013 | 0.0002 | 0.0012 | 0.0018 | 0.0005 | 0.0002 |
| Cell Periphery | 0.0002 | 0.0003 | 0.0001 | 0.0004 | 0 | 0 | 0.0001 | 0.0001 | 0 | 0 | 0.0001 | 0 | 0.0003 | 0 | 0.0002 | 0.0002 | 0.0001 | 0 |
| Cytoplasm | 0.8136 | 0.8536 | 0.9825 | 0.842 | 0.9891 | 0.9801 | 0.8774 | 0.9783 | 0.9537 | 0.993 | 0.912 | 0.9673 | 0.8342 | 0.9915 | 0.9419 | 0.8937 | 0.7469 | 0.9757 |
| Cytoplasmic Foci | 0.0236 | 0.0038 | 0.0008 | 0.0094 | 0.0027 | 0.0017 | 0.0132 | 0.007 | 0.003 | 0.0021 | 0.0172 | 0.0066 | 0.0217 | 0.0009 | 0.0047 | 0.014 | 0.0466 | 0.0032 |
| Eisosomes | 0.0002 | 0.0004 | 0 | 0.0003 | 0 | 0 | 0.0005 | 0 | 0 | 0 | 0.0001 | 0 | 0.0006 | 0 | 0.0002 | 0.0001 | 0.0007 | 0 |
| Endoplasmic Reticulum | 0.0171 | 0.0029 | 0.0097 | 0.0084 | 0.0011 | 0.0036 | 0.0095 | 0.0014 | 0.0008 | 0.0006 | 0.0032 | 0.0034 | 0.0207 | 0.0032 | 0.0024 | 0.0012 | 0.0031 | 0.0026 |
| Endosome | 0.028 | 0.0136 | 0.0012 | 0.0125 | 0.002 | 0.0023 | 0.0082 | 0.0005 | 0.0013 | 0.0021 | 0.0199 | 0.0073 | 0.0307 | 0.0007 | 0.008 | 0.0052 | 0.0271 | 0.003 |
| Golgi | 0.0046 | 0.0278 | 0.0001 | 0.0054 | 0.0001 | 0.0008 | 0.0051 | 0.0003 | 0.0013 | 0.0002 | 0.0101 | 0.0026 | 0.0091 | 0.0001 | 0.0029 | 0.0075 | 0.0148 | 0.0017 |
| Lipid Particles | 0.0137 | 0.0015 | 0 | 0.0146 | 0 | 0 | 0.0131 | 0.0001 | 0.0126 | 0 | 0.013 | 0.0001 | 0.0074 | 0 | 0.0041 | 0.0096 | 0.0389 | 0.0014 |
| Mitochondria | 0.001 | 0.0378 | 0.0004 | 0.0444 | 0.0001 | 0.0052 | 0.0022 | 0.0002 | 0.0006 | 0 | 0.0053 | 0.006 | 0.0084 | 0 | 0.0045 | 0.0107 | 0.0028 | 0.0004 |
| None | 0.0179 | 0.0006 | 0.0003 | 0.0026 | 0.0002 | 0.0003 | 0.0118 | 0.0006 | 0.0006 | 0.0002 | 0.0012 | 0.0004 | 0.0058 | 0.0003 | 0.003 | 0.0024 | 0.0154 | 0.0003 |
| Nuclear Periphery | 0.0084 | 0.0014 | 0.0013 | 0.0134 | 0.0006 | 0.0005 | 0.0126 | 0.0003 | 0.0002 | 0.0002 | 0.0006 | 0.0004 | 0.0067 | 0.0006 | 0.0008 | 0.0004 | 0.0051 | 0.0004 |
| Nucleolus | 0.0011 | 0 | 0 | 0.0003 | 0 | 0 | 0.0001 | 0 | 0 | 0 | 0 | 0 | 0.0004 | 0 | 0.0001 | 0.0003 | 0.0003 | 0 |
| Nucleus | 0.0033 | 0.0013 | 0.0015 | 0.0017 | 0.0013 | 0.0014 | 0.0015 | 0.0006 | 0.0005 | 0.0006 | 0.0008 | 0.0008 | 0.0028 | 0.0006 | 0.0009 | 0.0013 | 0.0009 | 0.0008 |
| Peroxisomes | 0.0075 | 0.0013 | 0 | 0.0021 | 0 | 0 | 0.0095 | 0.0004 | 0.0073 | 0 | 0.0029 | 0.0002 | 0.0032 | 0 | 0.0013 | 0.0134 | 0.0269 | 0.0005 |
| Punctate Nuclear | 0.0397 | 0.0002 | 0 | 0.0056 | 0.0001 | 0 | 0.0019 | 0.0005 | 0.0001 | 0 | 0.0006 | 0.0001 | 0.0019 | 0 | 0.0005 | 0.0004 | 0.0106 | 0.0001 |
| Vacuole | 0.0026 | 0.0023 | 0.0007 | 0.0049 | 0.0013 | 0.0005 | 0.0014 | 0.0003 | 0.0003 | 0.0003 | 0.0007 | 0.0006 | 0.003 | 0.0002 | 0.0028 | 0.0011 | 0.0008 | 0.0002 |
| Vacuole Periphery | 0.0006 | 0.0008 | 0.0003 | 0.0053 | 0.0003 | 0.0003 | 0.0007 | 0 | 0.0001 | 0.0001 | 0.0004 | 0.0002 | 0.0012 | 0 | 0.0011 | 0.0006 | 0.0008 | 0.0001 |
Sequencing Data
| R1 | R2 | |||||||||
|---|---|---|---|---|---|---|---|---|---|---|
| G1 Post-START | S/G2 | Metaphase | Anaphase | Telophase | G1 Post-START | S/G2 | Metaphase | Anaphase | Telophase | |
| Gene Expression | 57.673 | 52.5289 | 51.0092 | 68.1404 | 44.6772 | 74.6796 | 61.4721 | 68.1535 | 70.1116 | 65.5662 |
| Translational Efficiency | 3.3406 | 2.523 | 2.8654 | 2.4043 | 3.072 | 2.7292 | 2.1495 | 2.2184 | 2.3882 | 2.3327 |
Hit Data
| Dataset | Hit |
|---|---|
| Protein Concentration | ✘ |
| Protein Localization | ✘ |
| Gene Expression | ✘ |
| Translational Efficiency | ✘ |
Endocytosis
| Temp | Actin Patch (Sac6-tdTomato) | Cortical Patch (Sla1-GFP) | Late Endosome (Snf7-GFP) | Vacuole (Vph1-GFP) |
|---|---|---|---|---|
| 37℃ | ||||
| RT |
Cell Cycle Omics
CYCLoPs (Cdc37-GFP)
| Gene / Allele | Actin Patch (Sac6-tdTomato) | Cortical Patch (Sla1-GFP) | Late Endosome (Snf7-GFP) | Vacuole (Sac6-tdTomato) |
|---|
| Gene | Images |
|---|
| Gene | Images |
|---|
Images are not yet available
Images are not yet available